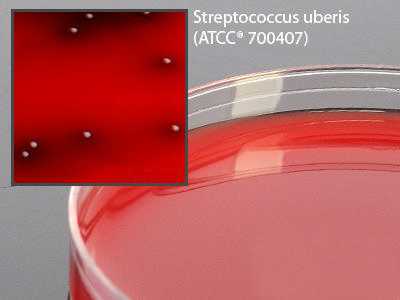

Media Tsa Bld/Esculin 15x100mm Plt 19 Ml , Pack Of 100
$ 131.83
|
|
Details:
Tryptic Soy Agar(TSA), With Blood and 0.1% Esculin, 15x100mm plate, Fill volume: 19ml^
Additional Information
| SKU | 23958764 |
|---|---|
| UOM | Pack of 100 |
| UNSPSC | 41104307 |
| Manufacturer Part Number | A19BX |
| Product Dimensions | 8X8X8 Inches |
| Product Weight | 8 |
